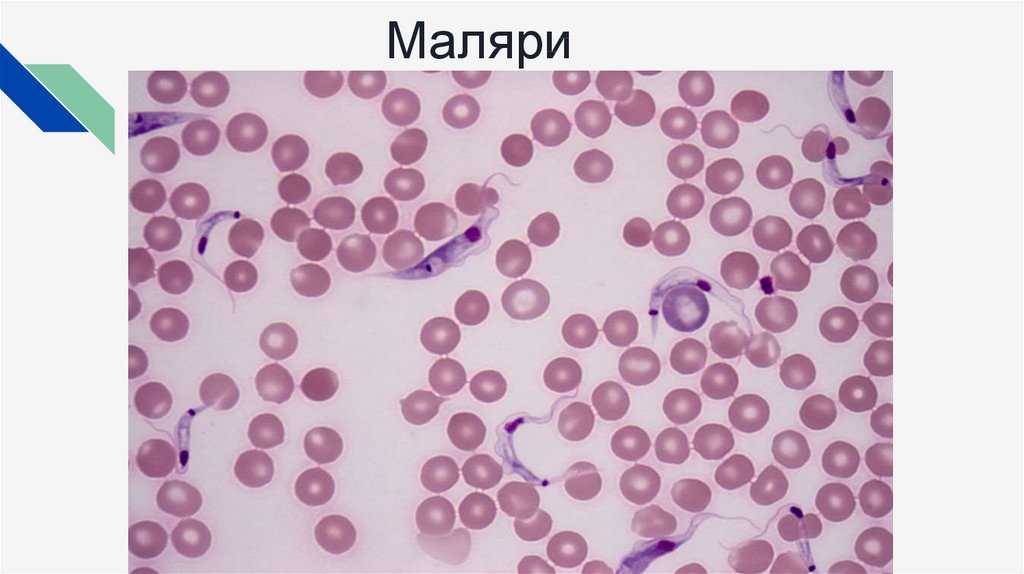

Похожие презентации:
Значение простейших в природе и жизни человека
1.
Значение простейших вприроде и жизни человека
Над презентацией работали: Глущенко Виктория, Ярославцева Анна
7 “1” класс
2.
1. Простейшие являются источником питания для другихживотных.
2. Простейшие выполняют роль санитаров, очищая водоемы
от бактерий и гниющих веществ.
3. Они служат индикаторами чистоты воды.
4. Они служат руководящими формами при разведке газа и
нефти.
5. Простейшие участвуют в образовании залежей
известняков.
6. Они участвуют в круговороте веществ.
7. Простейшие оказывают влияние на
почвообразовательные процессы.
8. Они являются возбудителями заболеваний домашних
3.
Лямблиоз4.
Малярия
5.
Амебиаз
6.
Токсоплазмоз
7.
Бабезиоз

Биология
Биология








